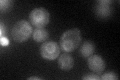
YIR004W
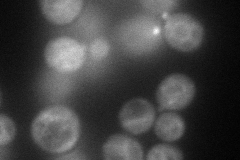
YIR004W
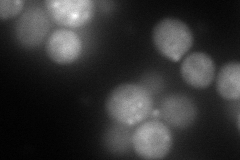
YIR004W
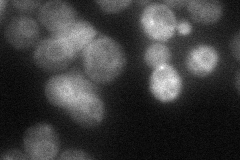
YIR004W
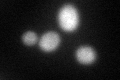
YIR004W
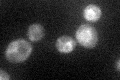
YIR004W

View description
Cytosolic J-domain-containing protein, required for peroxisomal protein import and involved in peroxisome assembly, homologous to E. coli DnaJ
Localization:
Intensity:
Fold change:
Significance:
-
C’ GFP library in SD
ER38.87 -
N' NOP1pr-GFP in SD
vacuole membrane,bud neck120.462 -
N' TEF2pr-mCherry in SD
ER,punctate,bud163.645 -
N' NATIVEpr-GFP in SD
ER39.6209 -
N' TEF2pr-VC and Cyto-VN in SD

cytosol59.8336 -
C’ GFP library in SD+DTT
ER44.661.14No -
C’ GFP library in SD+H2O2
ER36.190.93No -
C’ GFP library in Starvation Media

ER54.891.41Yes -
C’ GFP library on the background of Pup2-DaMP

ER -
C’ GFP library on the background of CCT mutant

ER36.52530.939526No
